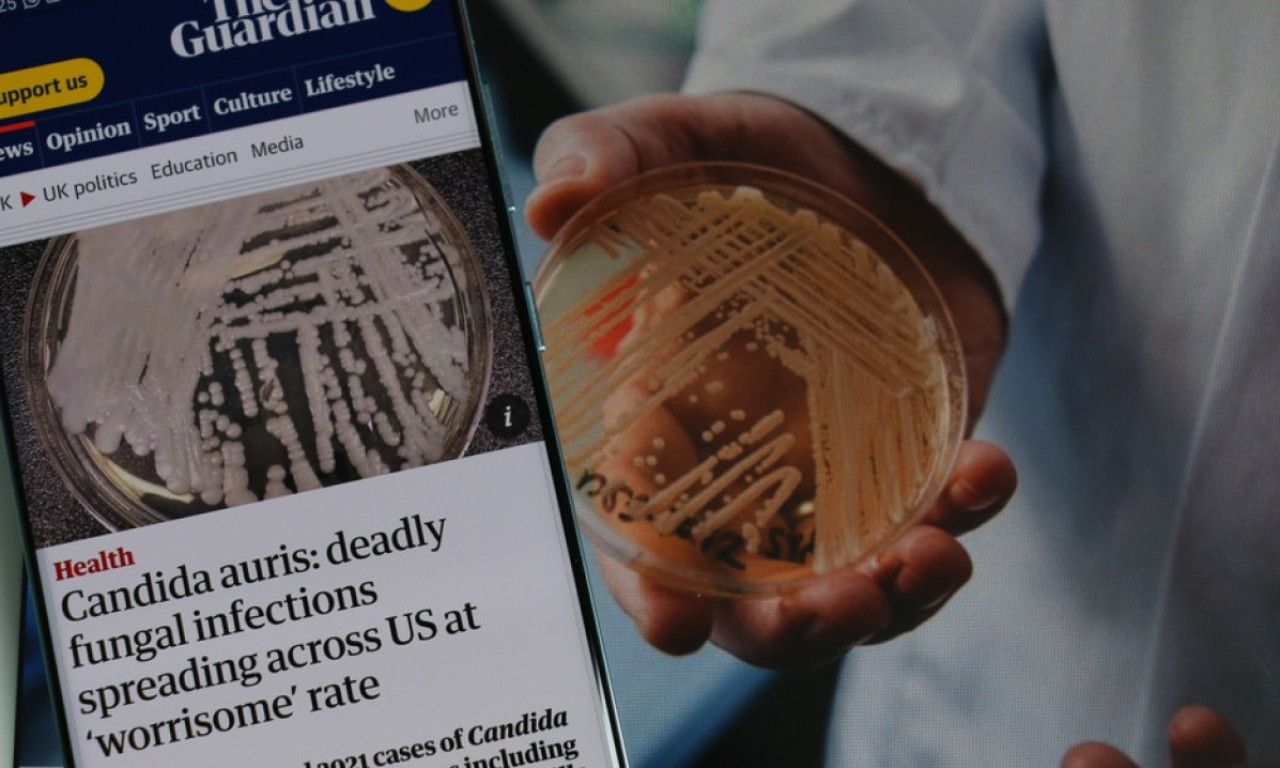
Nova GLOBALNA PRETNJA ZDRAVLJU stiže iz Amerike: Ova gljivična infekcija ima STOPU SMRTNOSTI između 30 i 60 posto

ZBOG PEDIKIRA ZAVRŠILA U BOLNICI Opasan alat u salonima može izazvati ozbiljne zdravstvene probleme!
Pre nego što se odlučite za određeni tretman, informišite se o korišćenim alatima i tehnikama, i uvek birajte salone sa visokim standardima
07.02.2025
VestiSPAVATE U ČARAPAMA? Ova navika može ozbiljno ugoziti vaše zdravlje upozoravaju lekari
Ako često imate hladna stopala, isprobajte prirodne metode zagrevanja, a nošenje čarapa ostavite za budne sate
31.01.2025
VestiVIRUS PTIČIJEG GRIPA SE NEPRIMETNO ŠIRI Novi sojevi bi mogli da krenu od ove životinje
Više od 700 farmi je pogođeno
12.12.2024
Vesti"IZGUBIO SAM VID" Elton Džon otkrio kakvo mu je zdravstveno stanje nakon borbe sa infekcijom
Pevač je nedavno izjavio da samo delimično vidi na jedno oko.
02.12.2024
Svet"SLATKE KRASTE" vladaju plažama Hrvatske! Stručnjaci upozoravaju da se ZARAZA LAKO ŠIRI, a evo kako da je izbegnete
To je infekcija bakterijom Staphilococcus, njihov nazovu se 'slatke kraste', a češća kod dece ili onih sa oslabljenim imunitetom
28.07.2024
RegionPANIKA zbog OPASNE INFEKCIJE koju prenose KOMARCI: Oprez ako planirate PUTOVANJE ovde!
Direktor sajta Trevl helf (Travel Health) Dipti Patel poručio je onima koji planiraju putovanje u inostranstvo da odvoje trenutak i pobrinu
22.03.2024
SvetOpaka INFEKCIJA SE ŠIRI! Izaziva TOKSIČNI šok i SMRT!
Dok se smatra da su stariji ljudi pod većim rizikom, soj grupe A dovodi do više smrtnih slučajeva među pacijentima mlađim od 50 godina
21.03.2024
SvetDRAMA U KINI! Pojavila se NOVA INFEKCIJA? Žena PREMINULA od KOMBINOVANOG smrtonosnog gripa
Prijavila je simptome u obliku kašlja, bola u grudima i groznice
31.01.2024
SvetAko se OVI delovi "osećaju" znak je za UZBUNU: NEPRIJATAN miris TELA otkriva ozbiljne INFEKCIJE
Da li vas brine miris nekog dela tela? Evo šta može da znači ako neprijatnost dolazi iz ušiju, pupka ili usta
30.08.2023
VestiNova GLOBALNA PRETNJA ZDRAVLJU stiže iz Amerike: Ova gljivična infekcija ima STOPU SMRTNOSTI između 30 i 60 posto
Candida auris može da izazove teške bolesti krvotoka, rane i respiratorne infekcije.
28.07.2023
SrbijaPočinje sa TEMPERATUROM, ali... nije nimalo NAIVNO: Doktorka objasnila sve o NAJOPASNIJIM VIRUSIMA u LETOVALIŠTIMA
Na putu morate da imate probiotik. Koksaki ne može da se prenese putem klima uređaja
26.07.2023
Vesti